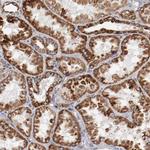
NDUFS4 Antibody in Immunohistochemistry (Paraffin) (IHC (P))

Search
Invitrogen
NDUFS4 Polyclonal Antibody
{{$productOrderCtrl.translations['antibody.pdp.commerceCard.promotion.promotions']}}
{{$productOrderCtrl.translations['antibody.pdp.commerceCard.promotion.viewpromo']}}
{{$productOrderCtrl.translations['antibody.pdp.commerceCard.promotion.promocode']}}: {{promo.promoCode}} {{promo.promoTitle}} {{promo.promoDescription}}. {{$productOrderCtrl.translations['antibody.pdp.commerceCard.promotion.learnmore']}}
产品信息
PA5-52010
种属反应
宿主/亚型
分类
类型
抗原
偶联物
形式
浓度
规格
纯化类型
保存液
内含物
保存条件
运输条件
RRID
产品详细信息
Immunogen sequence: RSLRTSTWRL AQDQTQDTQL ITVDEKLDIT TLTGVPEEHI KTRKVRIFVP ARNNMQSGVN NTKKWKMEFD TRERWENPLM GWASTADPLS NMVLTFSTKE DAVSFAEKNG WSYDIEERKV PKPKSKSYGA NFSWNKRTRV S
Highest antigen sequence identity to the following orthologs: Mouse - 92%, Rat - 91%.
靶标信息
This gene encodes an accessory subunit of the mitochondrial membrane respiratory chain NADH dehydrogenase (Complex I), or NADH:ubiquinone oxidoreductase, the first multi-subunit enzyme complex of the mitochondrial respiratory chain. Complex I plays a vital role in cellular ATP production, the primary source of energy for many crucial processes in living cells. It removes electrons from NADH and passes them by a series of different protein-coupled redox centers to the electron acceptor ubiquinone. In well-coupled mitochondria, the electron flux leads to ATP generation via the building of a proton gradient across the inner membrane. Complex I is composed of at least 41 subunits, of which 7 are encoded by the mitochondrial genome and the remainder by nuclear genes.
仅用于科研。不用于诊断过程。未经明确授权不得转售。
篇参考文献 (0)
生物信息学
蛋白别名: CI-18 kDa; CI-AQDQ; complex I 18kDa subunit; Complex I-18 kDa; Complex I-AQDQ; mitochondrial respiratory chain complex I (18-KD subunit); NADH dehydrogenase (ubiquinone) Fe-S protein 4 18kDa (NADH-coenzyme Q reductase) isoform NDUFS4_1; NADH dehydrogenase (ubiquinone) Fe-S protein 4 18kDa (NADH-coenzyme Q reductase) isoform NDUFS4_2; NADH dehydrogenase (ubiquinone) Fe-S protein 4, 18kDa (NADH-coenzyme Q reductase); NADH dehydrogenase [ubiquinone] iron-sulfur protein 4, mitochondrial; NADH-ubiquinone oxidoreductase 18 kDa subunit; subunit of Mitochondrial Complex I
基因别名: 6720411N02Rik; AQDQ; C1-18k; CI-18; CI-18 kDa; CI-AQDQ; MC1DN1; NDUFS4
UniProt ID: (Human) O43181, (Mouse) Q9CXZ1, (Rat) Q5XIF3
Entrez Gene ID: (Human) 4724, (Mouse) 17993, (Rat) 499529